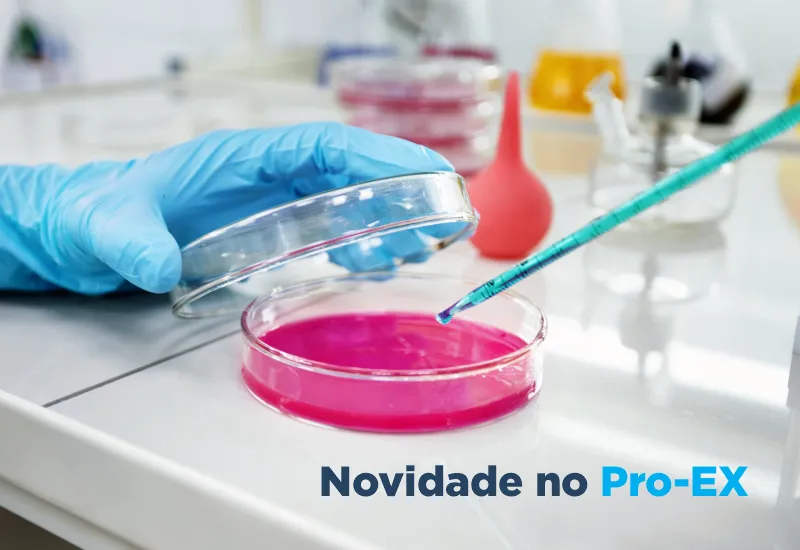
Novo Programa Avançado em Cultura de Identificação para <i>Neisseria gonorrhoeae</i>

Notícias
Últimos Posts
Como separar e destinar adequadamente resíduos químicos laboratoriais
Gestão de resíduos químicos laboratoriais Os resíduos químicos laboratoriais são substâncias, ou mistura de substâncias, com potencial de causar danos a organismos vivos ou ao meio ambiente. Muitos resíduos ainda podem tornar-se...
» Leia MaisNovembro Azul
O PSA é um dos primeiros exames solicitados quando o paciente apresenta sintomas do câncer ou quando o médico deseja pesquisar a existência da doença, mesmo sem a presença de sintomas.O Antígeno Prostático Específico, mais conhecid...
» Leia MaisPipeta: 10 dicas para você cuidar bem do seu equipamento
A pipeta (ou micropipeta) é um equipamento indispensável na rotina laboratorial. Por isso, incluir em seu dia a dia boas práticas de uso podem ajudar a aumentar a vida útil de sua pipeta, além de contribuir para a assertividade de suas...
» Leia MaisA avaliação anual do seu laboratório no PRO-EX já está disponível!
O PNCQ envia mensalmente um kit PRO-EX aos Laboratórios Participantes, totalizando 12 kits ao ano (de outubro a setembro do ano seguinte) e o laboratório deve enviar ao PNCQ, no mínimo, os resultados de 11 dos 12 lotes do PRO-EX contrata...
» Leia MaisPesquisa Nacional sobre Gestão de Riscos em Laboratórios Clínicos
Participe da Pesquisa Nacional sobre Gestão de Riscos em Laboratórios Clínicos promovida pela Comissão de Estudos para a nacionalização da norma técnica ISO 22367. O objetivo da pesquisa é avaliar o conhecimento sobre Gestão de ...
» Leia MaisMonkeypox: teste molecular é incorporado ao rol de procedimentos com cobertura obrigatória pelos planos de saúde
O teste diagnóstico para monkeypox (doença nomeada anteriormente como varíola dos macacos) foi aprovado para inclusão ao Rol de Procedimentos e Eventos em Saúde na tarde dessa segunda-feira, 19/09, durante reunião da Diretoria Colegia...
» Leia MaisNotificação compulsória – Varíola dos macacos
A notificação compulsória é a comunicação obrigatória à autoridade de saúde sobre a ocorrência de suspeita ou confirmação de doença, agravo ou evento de saúde pública. Deve ser realizada pelos médicos, profissionais de saúd...
» Leia MaisLei Geral de Proteção de Dados
Você já deve ter ouvido falar sobre a Lei Geral de Proteção de Dados, promulgada sob nº 13.709/18, uma lei brasileira que busca regulamentar o tratamento de dados pessoais por todos aqueles que, de alguma forma, captam informações se...
» Leia MaisManual técnico para o diagnóstico da sífilis 2ª ed.
O Departamento de Doenças de Condições Crônicas e Infecções Sexualmente Transmissíveis, da Secretaria de Vigilância em Saúde, do Ministério da Saúde publicou, em 2021, a 2ª edição do Manual técnico para o diagnóstico da síf...
» Leia MaisNovo Programa Avançado em Cultura de Identificação para <i>Neisseria gonorrhoeae</i>
Já está disponível o novo Programa Avançado de Controle Externo de Qualidade PRO-EX em Cultura de Identificação para Neisseria gonorrhoeae. Se o seu laboratório realiza esse exame, deve realizar também o controle externo de qual...
» Leia MaisBusca
Últimos Posts
Categorias

Inscreva-se para receber Informativos
Nosso objetivo é facilitar a obtenção de informações a respeito do funcionamento do PNCQ e sobre Controle de Qualidade e Gestão da Qualidade no labotatório, assine e fique informado(a).